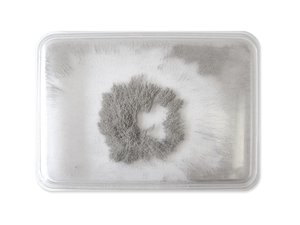
Rechthoek van magnetische experimenten
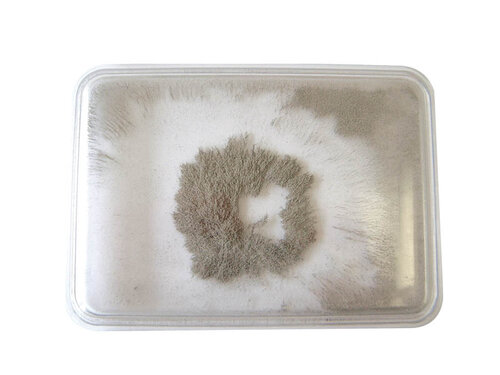
Rechthoek van magnetische experimenten

Natuurkunde
Bezig met laden...


Natuurkunde: De Kern van Educatie
Natuurkunde is de kern van wetenschappelijk begrip en de sleutel tot het verkennen van de wereld om ons heen. Op scholen speelt het een essentiële rol in het stimuleren van nieuwsgierigheid en het ontwikkelen van analytische vaardigheden bij leerlingen. Met de demonstratie modellen en de vele natuurkundige materialen van Rybka.nl krijgen leerlingen meer in zicht in de natuurkunde
Natuurkunde in de klas
Bij Rybka.nl hebben we een scala aan innovatieve educatieve materialen ontwikkeld die leraren helpen om natuurkunde tot leven te brengen in het klaslokaal. Onze Elektriseermachine van Wimshurst biedt praktische experimenten die leerlingen betrekken bij het begrijpen van elektromagnetische fenomenen. Met de Optica Set kunnen ze experimenteren met lichtbreking en lenzen, terwijl het professioneel tellurium hen in staat stelt om astromonische verschrijnselen te verklareb. Ontdek onze vele andere hoogwaardige producten en inspireer je leerlingen vandaag nog!
Educatieve natuurkunde materialen kopen
Door natuurkunde materialen te kopen van Rybka.nl, profiteren scholen van hoogwaardige producten die zijn ontworpen om leerlingen te inspireren en te betrekken bij wetenschappelijk leren. Met onze educatieve hulpmiddelen kunnen leraren complexe concepten op een begrijpelijke manier uitleggen, waardoor leerlingen actief betrokken raken bij hun leerproces. Bovendien bevorderen onze materialen hands-on leren, wat resulteert in een dieper begrip en langdurige educatieve impact.
Laatst bekeken producten

Klantenservice
Vragen of opmerkingen?
Neem contact met ons op!
+31 (0)72 511 2902
ma-vr: van 09:00 t/m 18:00
of mail naar: info@rybka.nl